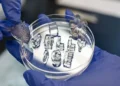
Quand la "glace en gelée" réutilisable garde les choses froides - sans fondre

Sono Motors, l’entreprise qui vise à révolutionner l’avenir du transport à énergie solaire, étend son activité dans ce domaine en entrant sur le marché en pleine croissance des remorques frigorifiques à travers sa technologie propriétaire Sono Solar, afin de réduire encore les émissions mondiales provenant des carburants fossiles. La société vient ainsi de signer un contrat d’achat avec The Reefer Group, leader international du marché de la carrosserie frigorifique.
Dans le cadre de cette collaboration, les deux entreprises vont construire une première remorque avec Chereau S.A.S., filiale française de The Reefer Group, en vue de vastes tests destinés à évaluer de manière approfondie la faisabilité technique et économique de l’intégration d’une solution solaire spécialement adaptée sur un véhicule de grande série.
La technologie solaire intégrée fournira à l’unité frigorifique de la remorque une puissance crête supplémentaire de 9,8 kW. Elle offrira la possibilité d’économiser environ 3416 litres de carburant (jusqu’à 8475 dans les conditions optimales) et réduira les émissions locales de CO2 de près de 9 tonnes par an et par véhicule par rapport aux remorques frigorifiques diesel .
« Ce partenariat représente une avancée considérable pour Sono Motors car il ouvre un tout nouveau débouché pour notre technologie propriétaire extrêmement polyvalente Sono Solar. Nous proposons une plate-forme légère et adaptable, idéale pour les remorques frigorifiques qui permet aux transporteurs de réduire les coûts et les émissions de l’ensemble de leur flotte. Nous sommes ravis de cette opportunité de collaborer avec un partenaire aussi réputé que Chereau et de pouvoir œuvrer à ses côtés à la création d’un avenir plus durable », commente Laurin Hahn, cofondateur et CEO de Sono Motors. « Nous nous réjouissons de toutes les opportunités que ce partenariat pourra susciter. »
« Les solutions d’intégration solaire fournies par Sono Motors sont parfaitement adaptées à nos remorques. Nous sommes heureux de pouvoir travailler avec Sono Motors à la création du futur prototype qui sera intégré à notre flotte de démonstration de remorques durables Reefer. Il s’agit d’un grand pas vers une mobilité commerciale plus durable et une réduction des émissions », ajoute Damien Destremau, PDG de The Reefer Group et directeur général de Chereau.
Une première remorque solaire à IAA Transportation 2022
Sono Motors va équiper le toit et les flancs d’une remorque Chereau existante avec 54 modules photovoltaïques selon le procédé VaPV (vehicle applied photovoltaic), spécialement conçu pour l’utilisation dans les véhicules de fret tels que la semi-remorque frigorifique Chereau. Les modules solaires automobiles à haute efficacité couvrent une superficie de 58,9 m2 et délivrent jusqu’à 9,8 kWc d’énergie au total en puissance crête. La première remorque sera dévoilée au salon IAA Transportation 2022 à Hanovre. Elle sera suivie de tests intensifs menés sur le terrain pendant plusieurs mois par un client de Chereau en France.
Un grand potentiel pour le solaire sur le marché de la carrosserie frigorifique
Le marché des remorques frigorifiques devrait connaître une forte croissance en raison de la demande croissante dans les secteurs des produits pharmaceutiques, des surgelés et de la restauration rapide. En outre, les coûts du carburant sont en hausse et la pression s’intensifie sur les prix. Sono Motors lutte contre le renchérissement du carburant et les émissions de CO2 avec sa technologie solaire d’une grande efficacité.
A propos de Sono Motors
Sono Motors se donne pour mission pionnière d’accélérer la révolution de la mobilité en propulsant chaque véhicule à l’énergie solaire. Sa technologie solaire révolutionnaire a été conçue pour permettre une intégration transparente dans tous les types de véhicules afin de réduire l’impact des émissions de CO2 et d’ouvrir la voie à une mobilité respectueuse du climat.
Sono Motors développe le Sion, premier véhicule électrique solaire (SEV) au monde pour le marché grand public. Avec l’appui d’une forte communauté, la société a collecté plus de 17 000 réservations prépayées. Ces véhicules seront fabriqués en sous-traitance.
La technologie solaire propriétaire de Sono Motors a été pensée pour faciliter son intégration et son exploitation sous licence dans un large éventail d’architectures de véhicules allant bien au-delà du Sion : bus, remorques, camions, camping-cars, trains, bateaux.
A propos de Chereau
Spécialisé dans la conception et la fabrication de véhicules frigorifiques, Chereau est reconnu par l’ensemble de la profession pour la grande qualité, la longévité et les performances de premier ordre de ses produits.
Expert européen des semi-remorques et véhicules frigorifiques, Chereau se singularise par une politique d’innovation permanente et des véhicules sur mesure et durables, au service des transporteurs les plus exigeants et des marchandises dont ils ont la responsabilité. Premier fabricant européen de poids-lourds frigorifiques, Chereau répond à tous les besoins des entreprises de transport routier – surgelés, produits pharmaceutiques, etc. – en proposant différents types de véhicules (semi-remorques, tracteurs rigides et autres). En 2021, Chereau a produit 3 600 véhicules, dont 3 000 remorques.